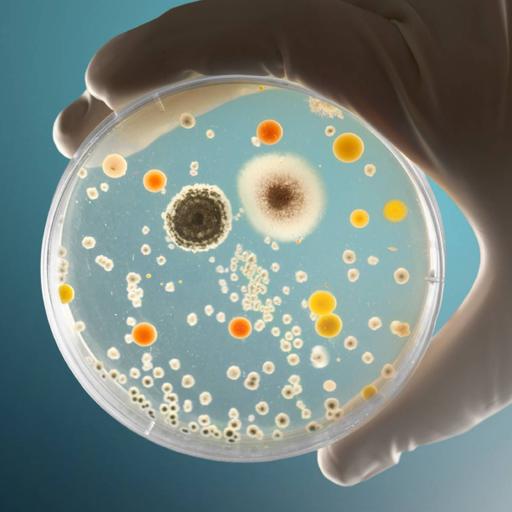

Della Mariya Davis
52 resources
She is a creative communicator dedicated to producing engaging content for online and offline platforms. She is a Post-Graduate in zoology and is presently also pursuing her M. Ed and graphic designing course.
View more